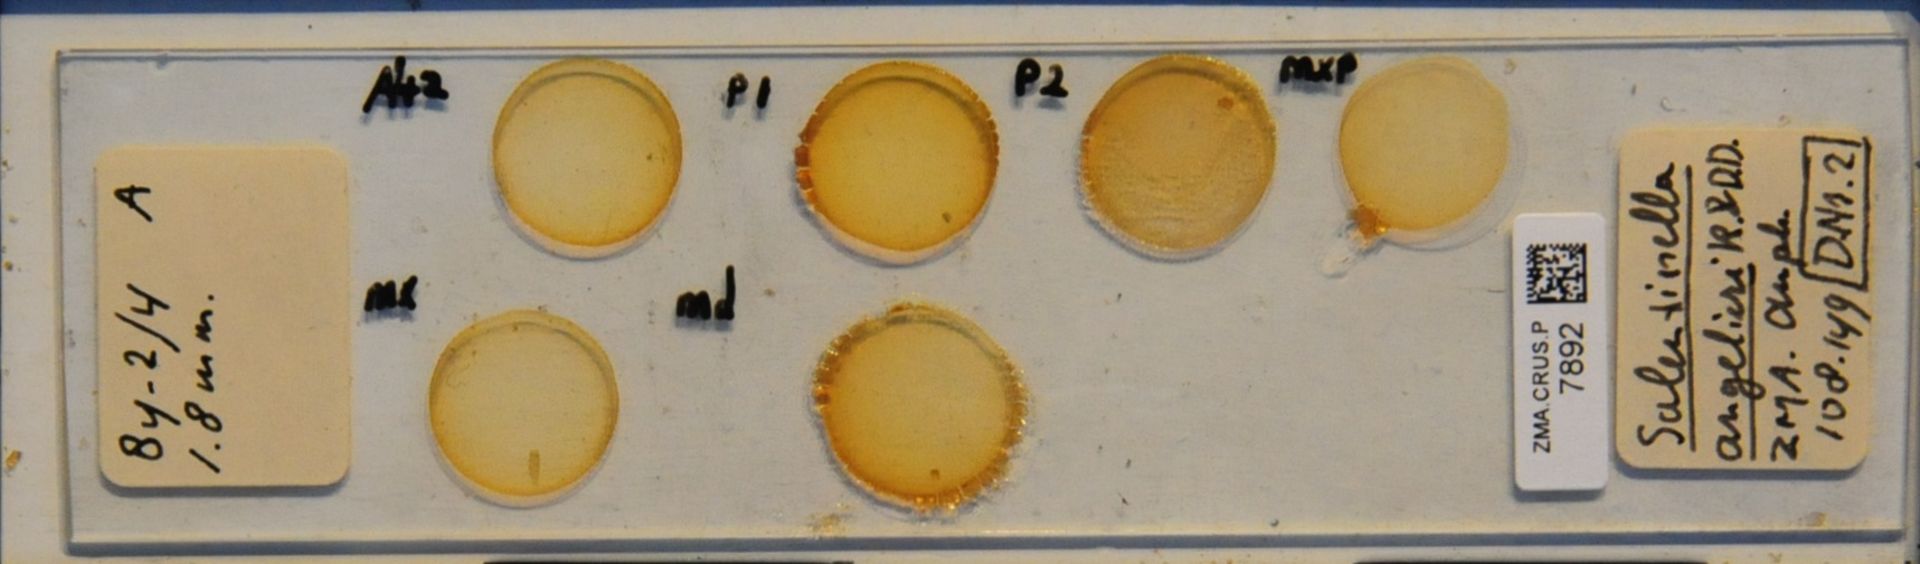

Espèces 33 à 48 sur 217
Niphargus virei
Chevreux, 1896
11 occurrences
11 medias

Abludogammarus flavus
Dybowsky, 1874
1 occurrences
1 medias

Salentinella angelieri
Ruffo & Delamare Deboutteville, 1952
34 occurrences
34 medias
Salentinella gineti
Balazuc, 1957
1 occurrences
1 medias

Talitroides alluaudi
Chevreux, 1896
28 occurrences
28 medias

Platorchestia platensis
Krøyer, 1845
250 occurrences
250 medias

Cryptorchestia cavimana
Heller, 1865
12 occurrences
12 medias

Cryptorchestia garbinii
Ruffo, Tarocco & Latella, 2014
71 occurrences
71 medias

Orchestia bottae
Milne Edwards, 1840
4 occurrences
4 medias

Bathynella natans
Vejdovsky, 1882
3 occurrences
3 medias

Parabathynella stygia
Chappuis, 1926
1 occurrences
1 medias

Paraiberobathynella fagei
Delamare Deboutteville & Angelier, 1950
2 occurrences
2 medias

Astacus astacus
Linnaeus, 1758
546 occurrences
546 medias

Austropotamobius pallipes
Lereboullet, 1858
498 occurrences
498 medias

Austropotamobius torrentium
Schrank, 1803
137 occurrences
137 medias

Pacifastacus leniusculus
Dana, 1852
1190 occurrences
1190 medias
